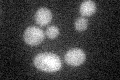
YDL045C
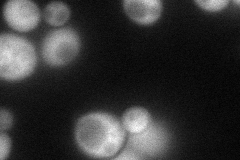
YDL045C
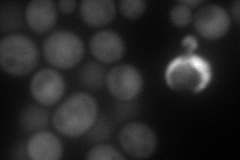
YDL045C
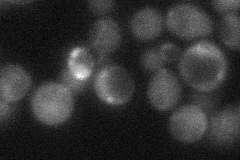
YDL045C
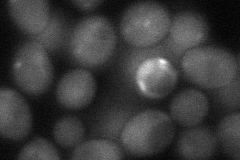
YDL045C
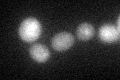
YDL045C

View description
Flavin adenine dinucleotide (FAD) synthetase, performs the second step in synthesis of FAD from riboflavin
Localization:
Intensity:
Fold change:
Significance:
-
C’ GFP library in SD
below threshold17.84 -
N' NOP1pr-GFP in SD
cytosol68.1861 -
N' TEF2pr-mCherry in SD
cytosol124.364 -
N' NATIVEpr-GFP in SD
cytosol27.8647 -
N' TEF2pr-VC and Cyto-VN in SD
nucleus46.722 -
C’ GFP library in SD+DTT
cytosol19.891.11No -
C’ GFP library in SD+H2O2

cytosol181No -
C’ GFP library in Starvation Media

cytosol20.021.12No -
C’ GFP library on the background of Pup2-DaMP

below threshold -
C’ GFP library on the background of CCT mutant

below threshold18.69061.04698No
